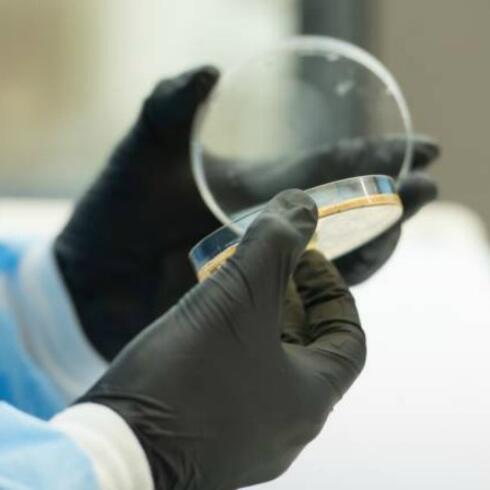

Yeshiva University






Skip past mobile menu to footer
Latest News
Featured News
Leadership Conference to Focus on the Jewish Family, Embracing its Strengths and Facing its Challenges ChampionsGate 2016, organized by Yeshiva University’s Center for the Jewish Future (CJF), will run from July 28 to July 31 in Orlando, Florida. The focus of the four-day conference will be “The ...

Yeshiva University Grants Tenure to Twenty Faculty Members The Yeshiva University Board of Trustees recently awarded tenure to 20 faculty members across the University’s undergraduate and graduate schools. The newly-tenured professors are Ronnie Perelis, Chief Rabbi Dr. Isaac Abraham and Jelena ...

Yeshiva University and Young Israel of Fort Lee Present Summer Learning Series with Dr. Jeffrey Gurock Yeshiva University’s Center for the Jewish Future (CJF) in collaboration with Young Israel of Fort Lee (YIFL) will present two lectures by Dr. Jeffrey Gurock, Libby M. Klaperman Professor of…

Rabbi Lord Jonathan Sacks Among Recipients of 2016 Bradley Prize On June, 15 2016, at a ceremony in Washington, D.C., Rabbi Lord Jonathan Sacks, Kressel and Ephrat Family University Professor of Jewish Thought at Yeshiva University, was awarded one of The Bradley Prizes by The Bradley Foundation ...
New York State Assemblyman Phillip Goldfeder to Lead Yeshiva University Government Relations Efforts Yeshiva University announced New York State Assemblyman Phillip Goldfeder will lead its government relations efforts beginning this fall. Goldfeder will work to strengthen and develop relationships…

Student-Run Summer Program Will Empower 200 Israeli Youth in Arad, Dimona and Kiryat Malachi For the eleventh straight year, Yeshiva University’s Center for the Jewish Future will run the Counterpoint Israel Program, an immersive service-learning initiative that aims to empower the next generation…
Scholarship Supports Advanced Undergraduate Research and Faculty Mentorship Five exceptional students have been selected as recipients of the 2016-17 Henry Kressel Research Scholarship. Established in 2008 by Dr. Henry Kressel, Yeshiva University chairman emeritus and a Yeshiva College alumnus—the…
Sy Syms Dean Selected to Take Part in 2016 Aspen Ideas Festival Dr. Moses Pava, dean of the Sy Syms School of Business and the Alvin Einbender Professor of Business Ethics, has been selected as an Arthur Vining Davis Foundations’ Aspen Fellow at the 2016 Aspen Ideas Festival June 26-29. The Fellows…

Yeshiva University High School for Girls Receives $191,000 for STEM Education The Samuel H. Wang Yeshiva University High School for Girls (Central) recently received $191,000 grant from the Gruss Foundation to put in place an innovative STEM program (science, technology, engineering, and…
YU Online Course for Communal Rabbis Explores Medical, Legal and Halachic Perspectives on Terminal Illness, End of Life Issues Yeshiva University's Center for the Jewish Future (CJF) and affiliate Rabbi Isaac Elchanan Theological Seminary (RIETS) have launched “Confronting End of Life Issues,” a ...
